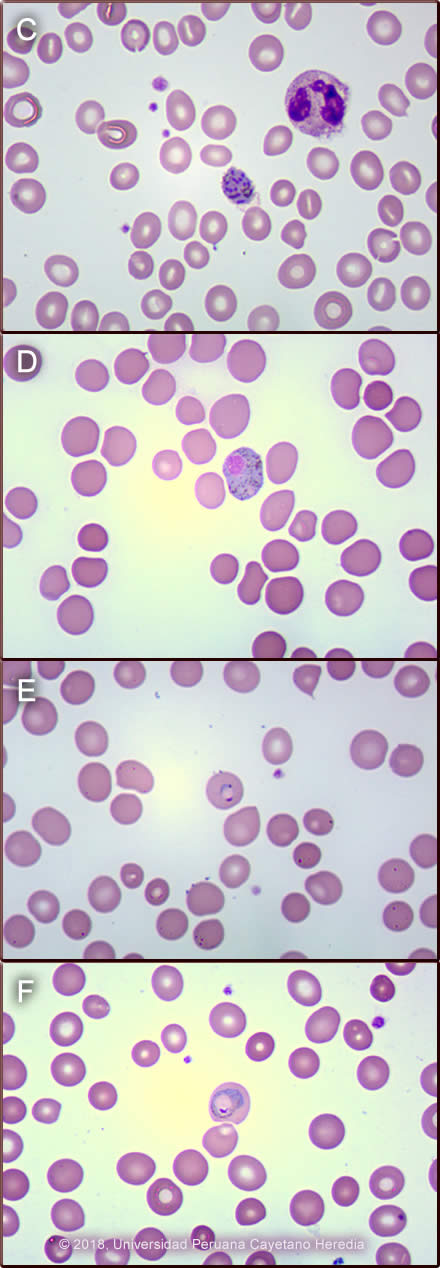
Images for Case 2018-06

|
Gorgas Case 2018-06 |
 |
|
The following case was seen on the inpatient ward of Cayetano Heredia Hospital in Lima by the 2018 Gorgas Course participants. 
 History: 45-year-old man was admitted with a 5-day history of generalized headache (6/10 intensity), body aches, and fever characterized as a very intense cold sensation with chills and rigors evolving into sweats and an intense hot feeling. Febrile episodes were continuous during the 5 days of the current illness. The day of admission the patient reports rigors, jaundice and onset of dark urine (Image A and B). Denies rash, arthralgia, mental status changes, bruising, bleeding or visual symptoms.
Past Medical History: Hospitalized 8 weeks earlier, in Iquitos in the Amazon region, for smear positive Plasmodium vivax for four days and treated with directly observed chloroquine base 600mg/day for 2 days and 300mg on the third day and primaquine 30 mg/day for 7 days. He returned to Lima for the final days of primaquine treatment. Ten years ago, he had malaria due to Plasmodium falciparum treated with artesunate 250mg/day for three days and mefloquine 750 mg/day for days 2 and 3 per the national protocol for P. falciparum. Epidemiology: Born and lived in Iquitos but moved to Lima 3 years ago. Traveled to Iquitos 27 days before the first hospitalization and stayed on a farm 8-hours by boat from the city. Denies any travel back to Iquitos since. No known TB contacts. Currently, there are cases of dengue, chikungunya, Zika, and leptospirosis in the region. Physical Examination on Admission: Patient presented to the ER, with normal mental status and in no apparent distress. BP: 110/70 mmHg. HR: 79 bpm. RR: 20 rpm. T: 37o C. Sat: 98 % (FiO2: 0.21) Skin: scleral icterus. Chest: clear to auscultation bilaterally, no crackles. Cardiovascular: regular heartbeat, no murmurs. Abdomen: soft, non-distended, normal bowel sounds heard, not tender to palpation; palpable tip of the spleen, no hepatomegaly. Neurological exam was normal. Laboratory Examination and Imaging: WBC 4.7 (3% bands, 48% segmented, 1% eosinophils, 4% monos, 43% lymphs). Hb 11.2g/dl, Hct 34%. Platelets 90 000. Glucose 119 mg/dl. Urea 19.2 mg/dl. Creatinine 1.02 mg/dl. Sodium 146mEq/L. Potassium 3.71mEq/L. Chloride 110 mEq/L. Total Bilirubin 3.93mg/dl. Direct Bilirubin 2.48mg/dl. ALT/AST 59/44UI/L. Gamma-glutamyltransferase 312UI/L. INR 0.98. TP 12.8. TTP 33.7. Abdominal ultrasound showed no hepatosplenomegaly. Chest x-ray: normal
UPCH Case Editors: Carlos Seas, Course Director / Karen Luhmann, Associate Coordinator UAB Case Editor: David O. Freedman, Course Director Emeritus / German Henostroza, Course Director |
|
Diagnosis: Relapse of Plasmodium vivax malaria.
Discussion: Thick film on admission showed P. vivax ++; schizonts that were easily seen throughout the smear (Image C) as well as P. vivax gametocytes. P. vivax characteristically shows parasitized red blood cells that are larger than non-parasitized ones and the membrane shows caveolae that take up the stain and appear as pink granules called Schüffner dots. Schizonts of P.vivax typically have 12-24 nuclei which will eventually be released as merozoites upon maturation and lysis of the red blood cell to infect new red blood cells. Gametocytes are the only life-cycle state that develop further after being ingested by mosquitoes. Macrogametocytes (female) of P. vivax are round to oval, have a compact nucleus and usually fill the host cell (Image D). Microgametocytes (male) (not shown here) are usually the size of an uninfected RBC and have a paler blue, pink or gray cytoplasm and a loose nucleus. Other forms seen in P. vivax are ring (Image E) and ameboid trophozoites (Image F). In cases of falciparum malaria only ring trophozoites +/- banana shaped gametocytes are seen in the peripheral blood, the other parasite stages are not seen because the parasitized RBC attaches to the endothelial cells in visceral capillaries and do not circulate in peripheral blood, except in severe infections where schizonts may be seen. The banana-shaped gametocytes are unique to P. falciparum and were not seen in this patient. The malaria parasite density is assessed under microscopic examination after reviewing 100 fields. A qualitative method for description is often used in Peru, where 2+ is defined when 2 - 20 parasites are seen per field in 100 fields, as in this case. The differential diagnosis in this case will include bacterial infections like typhoid fever, brucellosis or tuberculosis, but these diseases usually do not start with chills and rigors. Other possibilities could include viral hepatitis or a liver abscess, and other viral illnesses like dengue, Zika or chikungunya, but the incubation period of these latter diseases is usually not longer than two weeks. Leptospirosis is common in the jungle; however, the incubation period is shorter compared to this case, and the fever tends to have a biphasic presentation where it resolves for 1-3 days and then reappears. It is usually accompanied by myalgia, conjunctival suffusion and renal failure. In a febrile patient that has visited a malaria endemic area, malaria should be the first diagnosis until proven otherwise. Characteristically in malaria there is no leukocytosis, except in severe malaria, and there is usually anemia and thrombocytopenia, as in this case. Jaundice is also very common. Malaria is endemic in Peru, the overall incidence rate in 2017 was 0.03 per 1000 inhabitants. The Loreto Department concentrates 93% of the total number of cases with an incidence rate of 0.87 per 1000 habitants; 73% of these cases were due to P. vivax [Centro Nacional de Epidemiologia, Prevención y Control de Enfermedades, Ministerio de Salud, Peru, 2017]. Relapses are important contributors to illness and morbidity in Plasmodium vivax and P. ovale infections. Relapse prevention (radical cure) with primaquine is required for optimal management, control and ultimately elimination of Plasmodium vivax malaria. However, its use is problematic because of uncertainty, over the risks of primaquine induced hemolysis due to G6PD deficiency, that is why this should be tested before starting treatment. In Peru, and at least also in Brazil, G6PD deficiency is so rare [Mem Inst Oswaldo Cruz, Rio de Janeiro 2014; 109(5): 553-568] that testing is not routinely done or required by national policy, and that is why primaquine is freely administered without complications. On his initial presentation in Iquitos, this patient received 30mg per day of primaquine base to complete a total dose of 210mg over 7 days. Assuring proper elimination of hypnozoites depends on the total cumulative dose more than on the duration of treatment or the dosing schedule. The World Health Organization (WHO) recommends a total dose of 210mg (0.25 mg/Kg of primaquine base/day/14 days) [Malaria Journal 2011; 10:351-62], and the Centers for Disease Control and Prevention (CDC) recommends a total dose of 420mg (0.5 mg/Kg of primaquine base/day/14 days) [JAMA 2007; 297(20):2264-77]. In Oceania and Southeast Asia, the effective dose to kill hypnozoites is 420mg [Antimicrob Agents Chemother 2012; 56(4):2146-9]. The total dose should ideally be 6mg/Kg of weight [Am J Trop Med Hyg 1977; 26(3):562-3]. Accordingly, in this case, this patient weighed 70kg, so he should have received 420mg which likely accounts for his relapse. Other possible reasons to explain P. vivax relapses such as this, in addition to low cumulative dose of primaquine, is lack of compliance with treatment, which was not the case with this patient; use of poor quality antimalarial drugs [Malaria J 2016;15:302], or drug malabsorption, which was not proven in this case. This patient was treated after he arrived at our hospital with 4 doses of intravenous artesunate, while P. falciparum was being ruled out because of concern for severe P. vivax malaria in a jaundiced patient. After P. falciparum was excluded he received chloroquine base 600mg/day for 2 days and 300mg on the third day and primaquine 30 mg/day for 14 days. Fever resolved after 2 days of treatment and the smear cleared after 3 days. Criteria for severe malaria due to P. vivax, according to the latest WHO manual, are the same as for P. falciparum but do not include parasite density thresholds [Guidelines for the treatment of malaria, third edition, World Health Organization 2015]. Jaundice in P. vivax malaria is very common, and it is considered one criteria for severe malaria based on the guidelines. However, in clinical practice, these patients respond well to standard oral medications and do not need to be treated as severe cases. Therefore, some malaria experts believe that criteria for severe malaria in vivax or other non-falciparum species should be reviewed. |